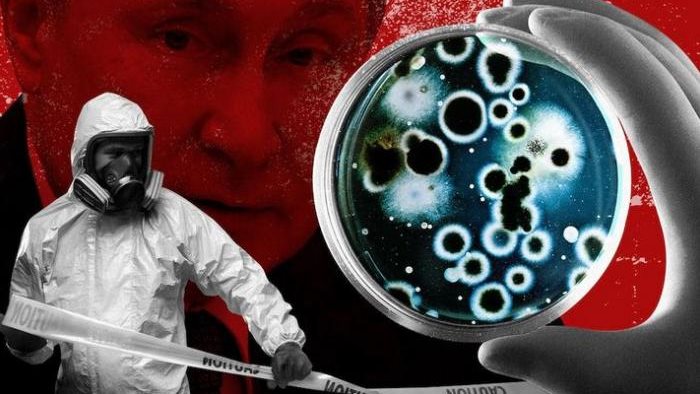

يعد مرض جدري القرود من أكثر الأمراض التى تثير قلق العلماء فى الوقت الراهن حيث أنه ينتشر بسرعة كبيرة في مناطق عديدة حول العالم .
ويسعى العلماء لفهم طبيعة مرض جدري القرود وكشف المزيد عنه للتمكن من الوقاية منه خاصة أن هناك بعض التوقعات بأن هناك بعض التغيرات طرأت على فيروس جدري القرود لذلك بدأ ينتشر بشكل مختلف تماما عن السابق حيث أنه موجود منذ سنوات عديدة فى قارة أفريقيا.
وللتمكن من الوقاية من مرض جدري القرود قدم مركز السيطرة على الأمراض الأمريكي “ CDC” عدة نصائح حول مرض جدري القرود.
لا تلمس الحيوانات التي يمكن أن تحمل الفيروس وليس القردة فقط بل جميع الحيوانات خاصة فى المناطق الموبوءة .
لا تلمس أي شئ يمكن أن يكون تلامس مع الحيوانات المريضة حتى الجماد.
الالتزام بعزل المرضى المصابين عن الآخرين المعرضين لخطر الإصابة تماما مثل عزل كورونا .
النظافة الجيدة لليدين بعد ملامسة الحيوانات المصابة أو البشر.
غسل يدين جيدا بالماء والصابون أو باستخدام معقم اليدين المعتمد على الكحول.
استعمال معدات الحماية الشخصية (PPE) عند رعاية المرضى.
لقاح JYNNEOSTM (المعروف أيضًا باسم Imvamune أو Imvanex) هو لقاح حي موهن ضد فيروس جدري القرود تمت الموافقة عليه من قبل إدارة الغذاء والدواء الأمريكية.